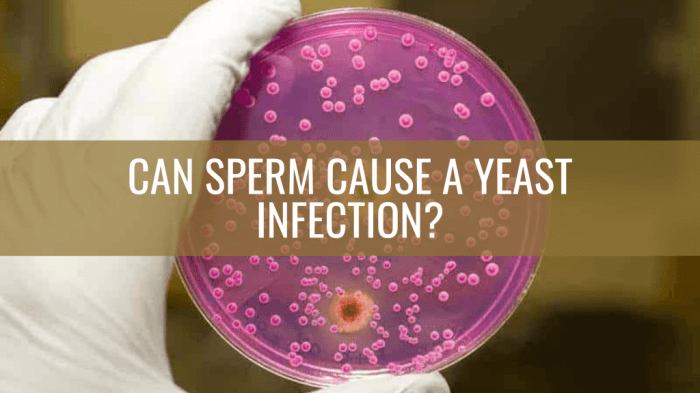

Can diet cause yeast infections? This question often arises when dealing with this common condition. While yeast infections are primarily caused by an overgrowth of the Candida fungus, certain dietary choices can influence its growth and contribute to the development of infections.
Understanding the connection between diet and yeast infections can empower individuals to make informed choices that promote vaginal health. This article will delve into the impact of different dietary components on yeast growth, explore specific dietary changes that may help prevent infections, and highlight the importance of consulting a healthcare professional for diagnosis and treatment.
Understanding Yeast Infections
Yeast infections, also known as candidiasis, are common fungal infections that can affect various parts of the body. These infections are caused by an overgrowth of a type of fungus called Candida, which is naturally present in small amounts on the skin, in the mouth, and in the digestive tract.
Causes of Yeast Infections
Yeast infections occur when the balance of naturally occurring bacteria and fungi in the body is disrupted, allowing Candida to multiply excessively. Several factors can contribute to this imbalance, including:
- Antibiotic use: Antibiotics can kill beneficial bacteria in the body, making it easier for Candida to overgrow.
- Hormonal changes: Fluctuations in hormone levels, such as those that occur during pregnancy or menopause, can increase the risk of yeast infections.
- Weakened immune system: Conditions that weaken the immune system, such as HIV/AIDS, diabetes, or certain medications, can make individuals more susceptible to yeast infections.
- Poor hygiene: Wearing tight-fitting clothing, using harsh soaps or detergents, or not wiping properly after using the bathroom can increase the risk of yeast infections.
- Certain medical conditions: Conditions such as diabetes, obesity, and chronic illnesses can increase the risk of yeast infections.
Symptoms of Yeast Infections
The symptoms of a yeast infection can vary depending on the location of the infection. Some common symptoms include:
- Vaginal yeast infection: Itching, burning, redness, and swelling of the vagina and vulva, as well as a thick, white, odorless discharge.
- Oral thrush: White patches on the tongue, inner cheeks, and roof of the mouth, which can be painful and make it difficult to eat or swallow.
- Yeast infection on the skin: Red, itchy, and scaly patches of skin, often in warm, moist areas like the groin, under the breasts, or between the fingers and toes.
Risk Factors for Yeast Infections
Several factors can increase the risk of developing yeast infections. These include:
- Pregnancy: Hormonal changes during pregnancy can increase the risk of vaginal yeast infections.
- Diabetes: High blood sugar levels can create a favorable environment for Candida to grow.
- Use of corticosteroids: Corticosteroids can suppress the immune system, making individuals more susceptible to infections.
- Weakened immune system: Conditions such as HIV/AIDS, cancer, or organ transplantation can compromise the immune system, increasing the risk of yeast infections.
- Antibiotic use: Antibiotics can disrupt the balance of bacteria and fungi in the body, making it easier for Candida to overgrow.
- Hormonal changes: Fluctuations in hormone levels, such as those that occur during menopause or due to certain medications, can increase the risk of yeast infections.
Diet and Yeast Infections
While yeast is naturally present in the body, certain dietary factors can influence its growth and contribute to yeast infections. Understanding how different foods impact yeast levels can help you make informed choices to maintain a healthy vaginal flora.
Sugar Intake and Yeast Infections
Yeast thrives on sugar, which it uses as a source of energy to multiply. A high intake of refined sugars, such as those found in processed foods, sugary drinks, and desserts, can create an environment conducive to yeast overgrowth. This is because sugar can increase the levels of glucose in the vagina, providing a readily available food source for yeast.
The Role of Probiotics in Maintaining a Healthy Vaginal Flora
Probiotics are beneficial bacteria that naturally occur in the gut and vagina. They help maintain a balanced vaginal flora by competing with yeast for space and resources. Consuming foods rich in probiotics, such as yogurt, kefir, sauerkraut, and kimchi, can help support a healthy vaginal environment and reduce the risk of yeast infections.
Foods that Might Contribute to Yeast Infections
Certain foods can contribute to yeast infections by providing a favorable environment for yeast growth. These foods include:
- Refined Sugars: Sugary drinks, candy, pastries, and processed foods.
- Yeast Extracts: Found in some processed foods, like bread, sauces, and soups.
- Fermented Foods: While some fermented foods are probiotic, some can contain high levels of yeast, such as certain types of bread, beer, and wine.
- High-Glycemic Foods: These foods cause a rapid spike in blood sugar levels, which can contribute to yeast overgrowth. Examples include white rice, potatoes, and white bread.
Foods that May Help Prevent Yeast Infections, Can diet cause yeast infection
Incorporating these foods into your diet can help maintain a healthy vaginal flora and reduce the risk of yeast infections:
- Probiotic Foods: Yogurt, kefir, sauerkraut, kimchi, and kombucha.
- Garlic: Contains antifungal properties that can help suppress yeast growth.
- Cranberries: May help prevent urinary tract infections, which can sometimes lead to yeast infections.
- Coconut Oil: Possesses antifungal properties and can be used topically to treat yeast infections.
Specific Dietary Changes and Yeast Infections
Dietary changes can significantly impact the occurrence and severity of yeast infections. By understanding the relationship between diet and yeast growth, you can make informed choices to manage and prevent these infections.
Low-Sugar Diets and Yeast Infections
Yeast thrives on sugar, and a diet high in simple sugars can create a favorable environment for its growth. A low-sugar diet can help reduce the availability of sugar for yeast, potentially mitigating the risk of infection. This diet emphasizes whole foods, lean proteins, healthy fats, and complex carbohydrates.
Eliminating Processed Foods and Refined Carbohydrates
Processed foods and refined carbohydrates are often high in sugar and lack essential nutrients. These foods can contribute to an imbalance in gut bacteria, potentially increasing the risk of yeast infections. By eliminating these foods, you can create a more balanced gut environment and support healthy vaginal flora.
Fermented Foods and Their Benefits
Fermented foods, such as yogurt, kefir, sauerkraut, and kimchi, are rich in probiotics. Probiotics are beneficial bacteria that can help restore the balance of the gut microbiome. A healthy gut microbiome can help prevent the overgrowth of yeast, reducing the risk of infection.
Balanced Diet for a Healthy Vaginal Flora
A balanced diet rich in fruits, vegetables, and whole grains provides essential vitamins, minerals, and fiber that support a healthy vaginal flora. These nutrients contribute to a healthy immune system and promote the growth of beneficial bacteria, which can help prevent yeast overgrowth.
Other Factors Contributing to Yeast Infections: Can Diet Cause Yeast Infection
While diet plays a role in yeast infections, several other factors can contribute to their development. These factors often interact with each other, making it challenging to pinpoint a single cause. Understanding these factors can help you make informed decisions about your health and prevent future infections.
Antibiotics and Yeast Infections
Antibiotics are powerful medications that kill bacteria. However, they can also disrupt the delicate balance of microorganisms in your body, including the vaginal flora. This disruption can lead to an overgrowth of yeast, as the bacteria that normally keep yeast in check are eliminated.
- If you are prescribed antibiotics, talk to your doctor about the potential for yeast infections and ask about preventive measures.
- Probiotics can help restore the balance of bacteria in your gut and vagina, which may reduce the risk of yeast infections after antibiotic use.
Hormonal Changes and Yeast Infections
Hormonal changes, particularly those associated with pregnancy and menopause, can increase the risk of yeast infections. During pregnancy, the body produces more estrogen, which can create a favorable environment for yeast growth. Similarly, during menopause, estrogen levels decline, which can also contribute to yeast overgrowth.
- Maintaining good hygiene practices, such as wearing breathable underwear and avoiding douching, can help prevent yeast infections during these hormonal shifts.
- If you experience recurrent yeast infections, talk to your doctor about potential hormonal factors and treatment options.
Stress and Yeast Infections
Stress can suppress the immune system, making it harder for the body to fight off infections, including yeast infections. Chronic stress can also disrupt the balance of hormones, which, as mentioned earlier, can contribute to yeast overgrowth.
- Managing stress through techniques like exercise, meditation, or yoga can help strengthen your immune system and reduce your risk of yeast infections.
- If you find yourself constantly stressed, talk to your doctor or a mental health professional about ways to cope with stress effectively.
Seeking Professional Advice
While dietary adjustments can play a role in managing yeast infections, it’s crucial to remember that they are not a substitute for professional medical advice. Consulting a healthcare professional is essential for accurate diagnosis and appropriate treatment.
When to Seek Medical Attention
Yeast infections can sometimes be mild and resolve on their own, but there are instances when seeking medical attention is crucial. It’s important to consult a doctor if you experience:
- Severe symptoms, such as intense itching, burning, or pain.
- Recurring yeast infections, especially if they occur frequently or persist despite home remedies.
- Yeast infections that are accompanied by other symptoms, such as fever, abdominal pain, or vaginal bleeding.
- You suspect you might have a different infection, such as a sexually transmitted infection (STI).
Potential Complications of Untreated Yeast Infections
While yeast infections are generally not life-threatening, leaving them untreated can lead to complications, including:
- Increased discomfort and pain: Untreated yeast infections can worsen symptoms, making daily activities challenging.
- Spread of infection: Yeast infections can spread to other areas of the body, such as the urinary tract or bloodstream, if left untreated.
- Increased risk of future infections: Untreated yeast infections can make you more susceptible to future infections.
- Impact on overall health: In some cases, untreated yeast infections can contribute to other health issues, especially if they affect the urinary tract or immune system.
Outcome Summary
In conclusion, while diet alone may not directly cause yeast infections, it plays a crucial role in maintaining a healthy vaginal flora. By making conscious dietary choices that support a balanced microbiome, individuals can reduce the risk of developing yeast infections. Remember, seeking professional advice from a healthcare provider is essential for proper diagnosis and treatment, especially if you experience persistent or recurring symptoms.
FAQ Overview
What are the most common symptoms of a yeast infection?
Common symptoms include vaginal itching, burning, redness, swelling, and a thick, white, odorless discharge.
How long does it typically take for a yeast infection to clear up with treatment?
With appropriate treatment, most yeast infections clear up within a week.
Can I prevent yeast infections with diet alone?
While diet plays a role, it’s not a guaranteed prevention method. Other factors, such as hormonal changes, antibiotic use, and weakened immune systems, can also contribute to infections.
Are there any foods I should avoid if I’m prone to yeast infections?
Foods high in sugar, processed foods, and refined carbohydrates are often associated with increased yeast growth.






















